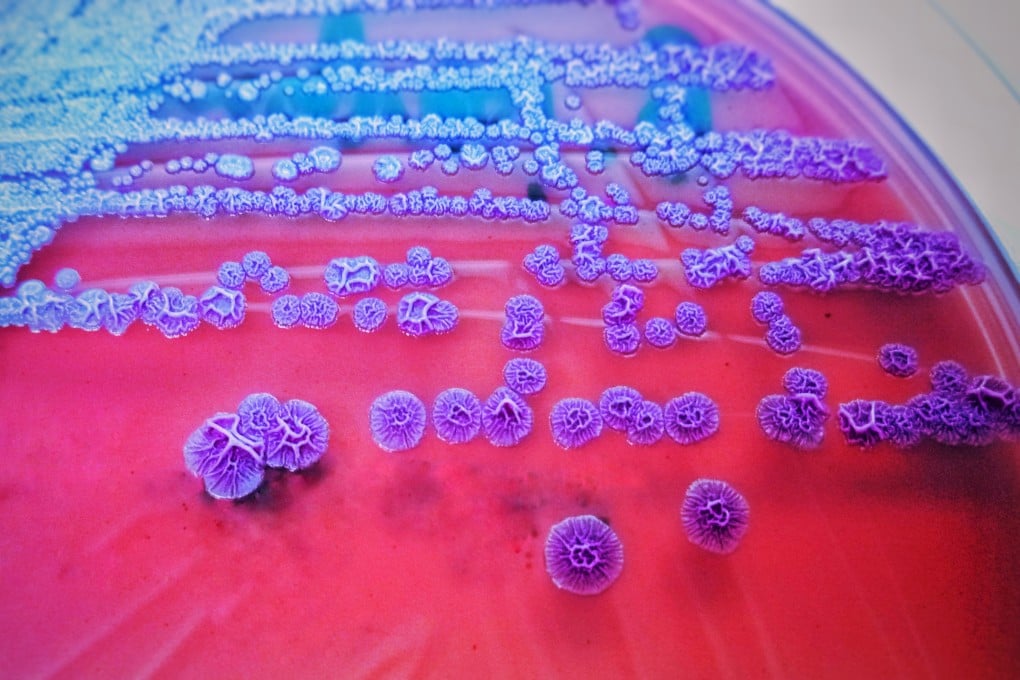
Fifteen cases of melioidosis were reported in West Kowloon between August and September this year. Photo: Shutterstock Images

Hong Kong logs ‘abnormal’ spate of melioidosis cases, but experts say chance of major outbreak slim
- Authorities report 15 cases of infectious disease in West Kowloon between August and September
- Disease usually spreads through contact with contaminated soil or surface water
Hong Kong health experts on Friday urged residents not to panic after authorities recorded an “abnormal” spate of melioidosis cases, saying the chance of a major outbreak was slim as person-to-person transmission was rare.
Caused by the bacterium Burkholderia pseudomallei, melioidosis is an infectious disease usually spread through contact with contaminated soil or surface water.
Fifteen cases of melioidosis, for which there is no vaccine and can be fatal, were reported in West Kowloon between August and September, accounting for just over half of the city’s total of 29 infections this year, according to the Centre for Health Protection. Twenty-three patients have been admitted to hospital, while six have died from the disease.

Last year, 17 cases of the disease were detected in the city. Ten cases on average have been logged each year over the past five years, according to official records.
“Over the past two decades, there have been about 100 cases in the city,” Dr Wilson Lam, vice-president of the Hong Kong Society of Infectious Diseases, said on a radio show. “If about 20 cases have emerged in the past few months, this is definitely a high record and an abnormal situation.”
Person-to-person transmission is rare, but can occur through contact with the blood or body fluid of an infected person. Symptoms include fever, headache and localised pain or swelling. Severe cases can involve pneumonia and sepsis.
The mortality rate ranges from 40 to 75 per cent, and there is currently no preventive vaccine targeting the bacteria. The disease is considered endemic in Southeast Asia and northern Australia.